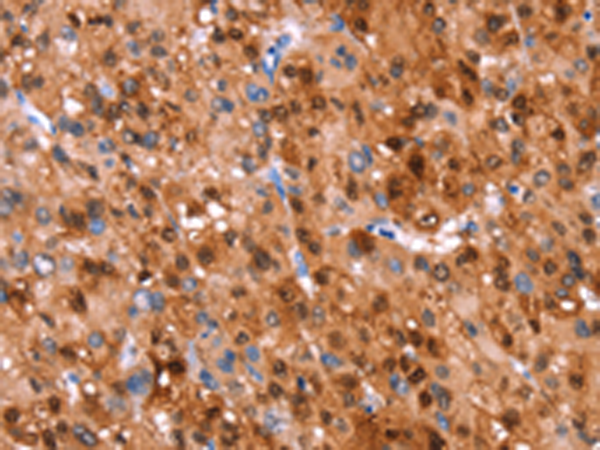

别名:GH; GHN; GH-N; hGH-N; IGHD1B应用:WB,IHC
反应种属:Human
规格:50μl/100μl
| Description |
|---|
| The protein encoded by this gene is a member of the somatotropin/prolactin family of hormones which play an important role in growth control. The gene, along with four other related genes, is located at the growth hormone locus on chromosome 17 where they are interspersed in the same transcriptional orientation; an arrangement which is thought to have evolved by a series of gene duplications. The five genes share a remarkably high degree of sequence identity. Alternative splicing generates additional isoforms of each of the five growth hormones, leading to further diversity and potential for specialization. This particular family member is expressed in the pituitary but not in placental tissue as is the case for the other four genes in the growth hormone locus. Mutations in or deletions of the gene lead to growth hormone deficiency and short stature. |
| Specification | |
|---|---|
| Aliases | GH; GHN; GH-N; hGH-N; IGHD1B |
| Swissprot | P01241 |
| WB Predicted band size | 25 kDa |
| Host/Isotype | Rabbit IgG |
| Storage | Store at 4°C short term. Aliquot and store at -20°C long term. Avoid freeze/thaw cycles. |
| Species Reactivity | Human |
| Immunogen | Synthetic peptide of human GH1 |
| Formulation | pH7.4 PBS, 0.05% NaN3, 40% Glycerol |
| Application | |
|---|---|
| WB | 1/200-1/1000 |
| IHC | 1/50-1/200 |
| ELISA | 1/1000-1/2000 |
 |
Gel: 10%SDS-PAGE, Lysate: 40 μg, Lane: Human placenta tissue, Primary antibody: P11784(GH1 Antibody) at dilution 1/500, Secondary antibody: Goat anti rabbit IgG at 1/8000 dilution, Exposure time: 1 second |
 |
The image is immunohistochemistry of paraffin-embedded Human brain tissue using P11784(GH1 Antibody) at dilution 1/40. (Original magnification: ×200) |
|
The image is immunohistochemistry of paraffin-embedded Human liver cancer tissue using P11784(GH1 Antibody) at dilution 1/40. (Original magnification: ×200) |
本公司的所有产品仅用于科学研究或者工业应用等非医疗目的,不可用于人类或动物的临床诊断或治疗,非药用,非食用。
暂无评论
本公司的所有产品仅用于科学研究或者工业应用等非医疗目的,不可用于人类或动物的临床诊断或治疗,非药用,非食用。
 中文
中文 








发表回复